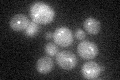
YDR425W
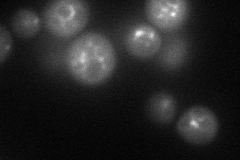
YDR425W
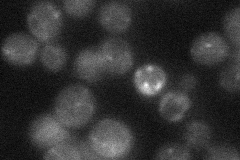
YDR425W
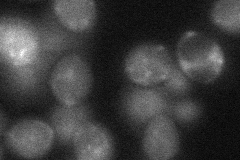
YDR425W

View description
Sorting nexin, involved in the retrieval of late-Golgi SNAREs from the post-Golgi endosome to the trans-Golgi network; interacts with Snx4p
Localization:
Intensity:
Fold change:
Significance:
-
C’ GFP library in SD
punctate25.53 -
N' NOP1pr-GFP in SD
punctate,vacuole membrane66.1789 -
N' TEF2pr-mCherry in SD

punctate28.2744 -
N' NATIVEpr-GFP in SD
punctate24.2977 -
N' TEF2pr-VC and Cyto-VN in SD
punctate33.4683 -
C’ GFP library in SD+DTT

punctate31.891.24No -
C’ GFP library in SD+H2O2

punctate33.161.29No -
C’ GFP library in Starvation Media

punctate34.911.36Yes -
C’ GFP library on the background of Pup2-DaMP

punctate -
C’ GFP library on the background of CCT mutant

punctate32.49431.27245No
